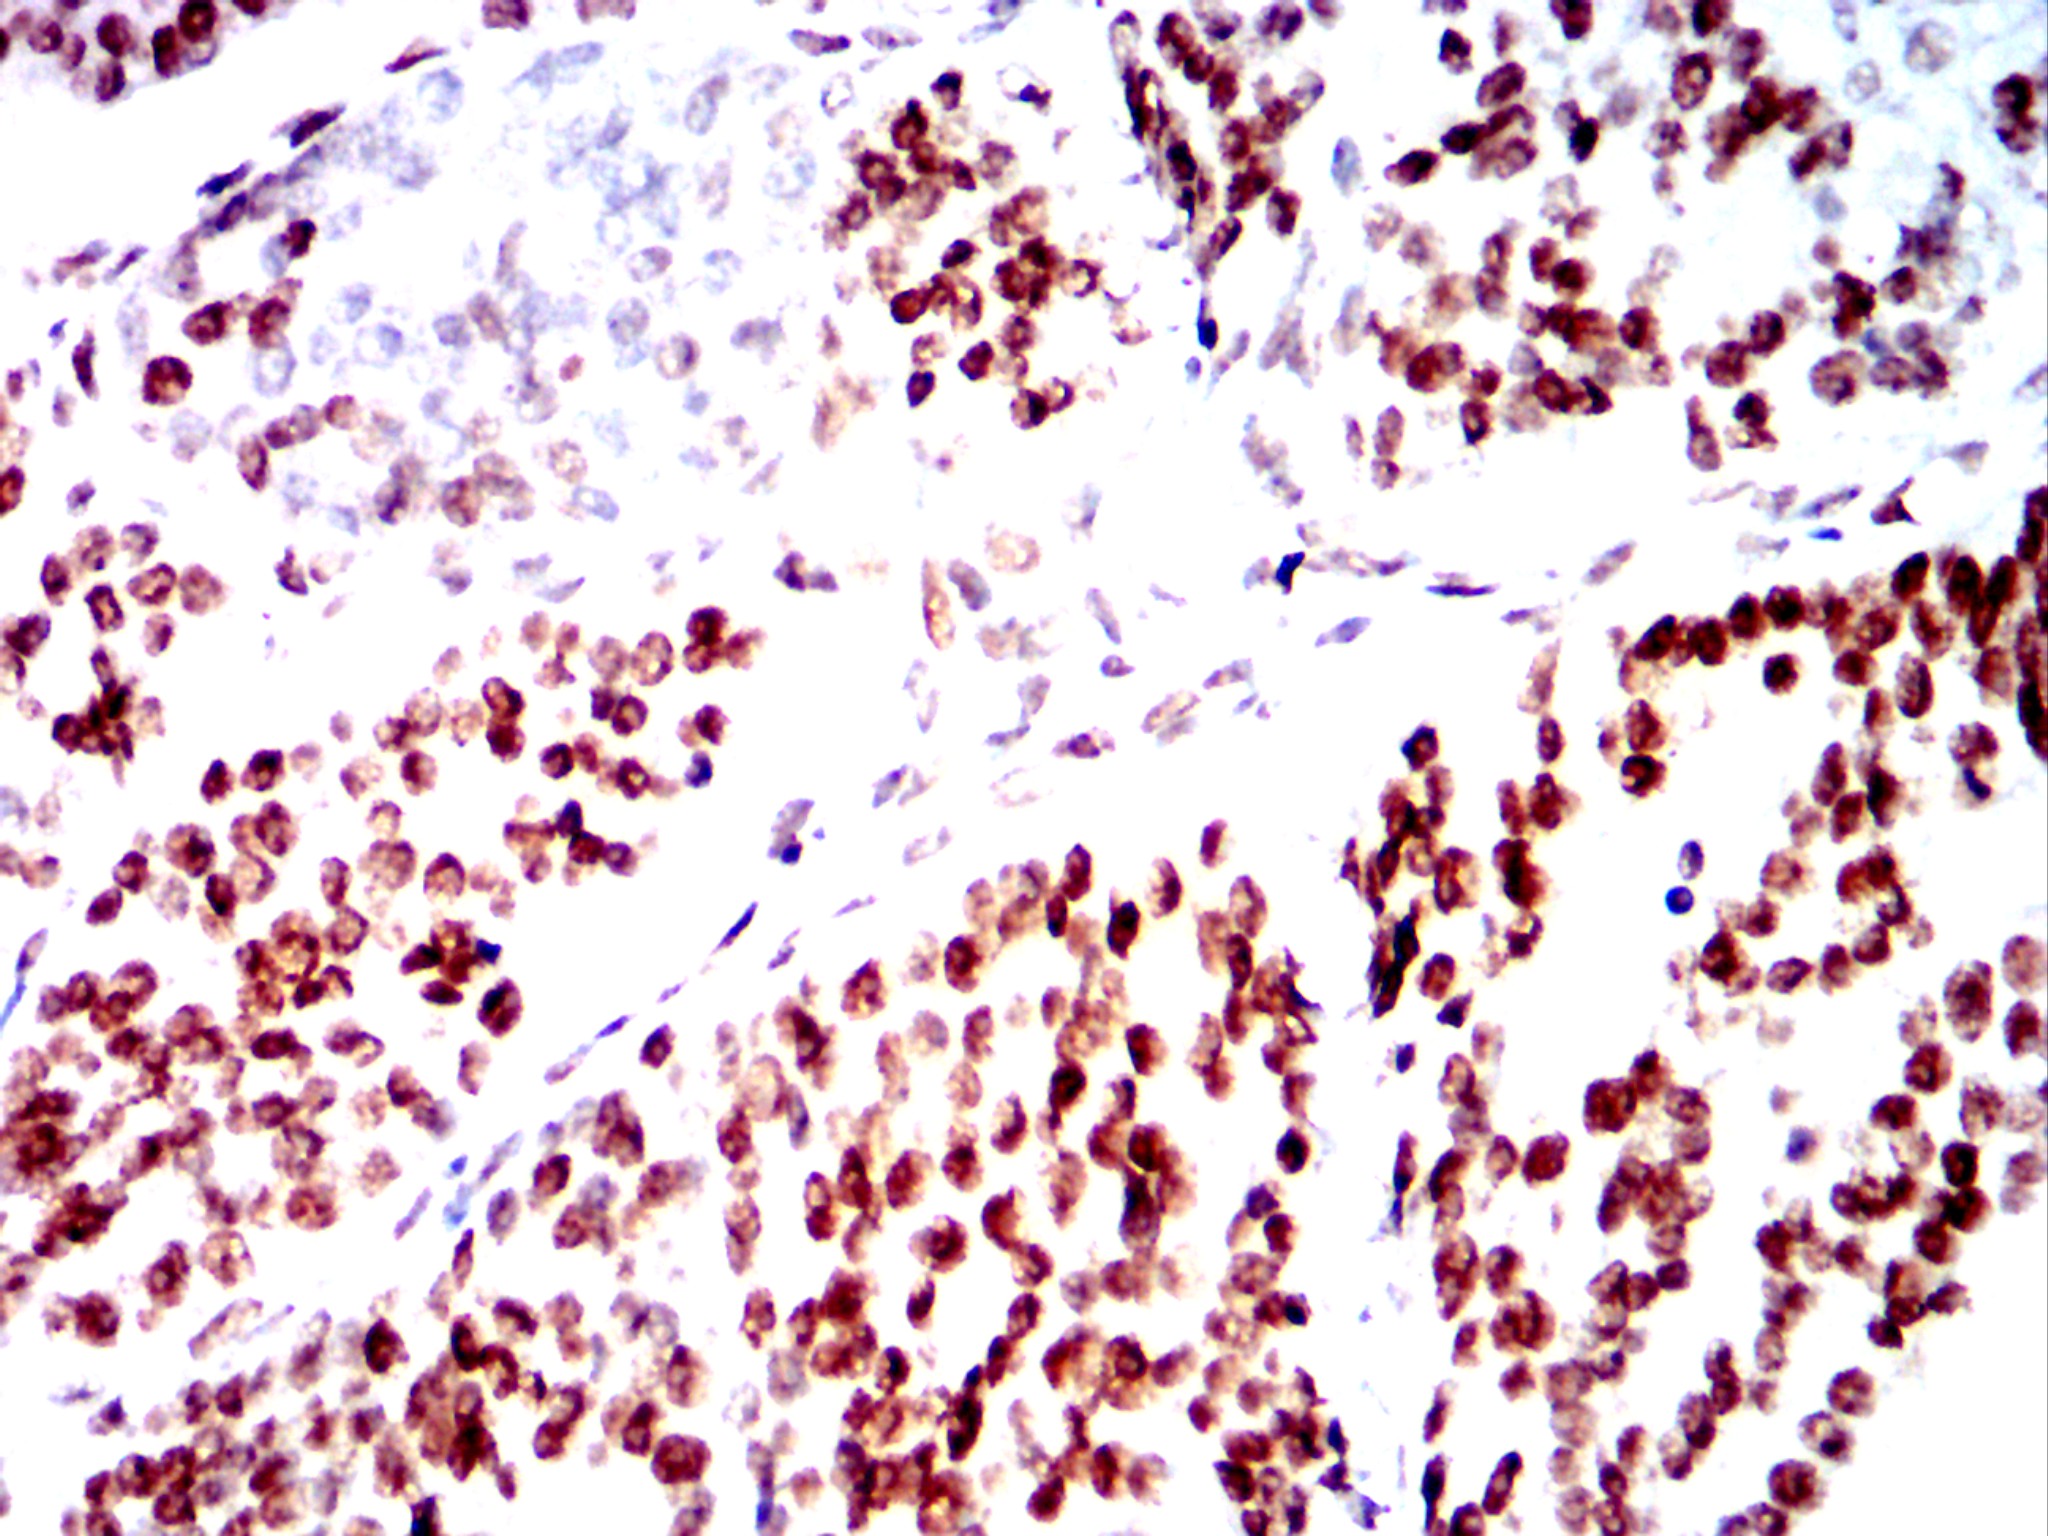

Mouse Monoclonal Antibody to SMARCA2
货号:
32447
别名:
BIS;BRM;SNF2;SWI2;hBRM;NCBRS;Sth1p;BAF190;SNF2L2;SNF2LA;hSNF2a
应用:
WB,IHC,IF,FCM
反应种属:
Human
抗体类型:
Primary antibody
Swissprot:
P51531
规格:
目录价
在线咨询
Description |
|---|
The protein encoded by this gene is a member of the SWI/SNF family of proteins and is highly similar to the brahma protein of Drosophila. Members of this family have helicase and ATPase activities and are thought to regulate transcription of certain genes by altering the chromatin structure around those genes. The encoded protein is part of the large ATP-dependent chromatin remodeling complex SNF/SWI, which is required for transcriptional activation of genes normally repressed by chromatin. Alternatively spliced transcript variants encoding different isoforms have been found for this gene, which contains a trinucleotide repeat (CAG) length polymorphism. [provided by RefSeq, Jan 2014] |
Specification |
|
|---|---|
| Aliases | BIS;BRM;SNF2;SWI2;hBRM;NCBRS;Sth1p;BAF190;SNF2L2;SNF2LA;hSNF2a |
| Entrez GeneID | 6595 |
| Swissprot | P51531 |
| clone | 10F4C9 |
| WB Predicted band size | 181.3kDa |
| Host/Isotype | Mouse IgG2a |
| Antibody Type | Primary antibody |
| Storage | Store at 4°C short term. Aliquot and store at -20°C long term. Avoid freeze/thaw cycles. |
| Species Reactivity | Human |
| Formulation | Purified antibody in PBS with 0.05% sodium azide |
Application |
|
|---|---|
| WB | 1/500-1/1000 |
| IHC | 1/200-1/400 |
| IF | 1/25-1/50 |
| FCM | 1/200 - 1/400 |
Product Image
-
Western blot analysis using SMARCA2 mouse mAb against Hela(1),HEK293(2),HepG2(3),A431(4)cell lysate.

-
Confocal Immunofluorescence analysis of HELA cells using SMARCA2 mouse mAb (green). Red: Actin filaments have been labeled with Alexa Fluor-555 phalloidin. Blue: DRAQ5 fluorescent DNA dye.

-
Confocal Immunofluorescence analysis of NIH3T3 cells using SMARCA2 mouse mAb (green). Red: Actin filaments have been labeled with Alexa Fluor-555 phalloidin. Blue: DRAQ5 fluorescent DNA dye.

-
Immunohistochemical analysis of paraffin-embedded human colon cancer tissues using SMARCA2 mouse mAb with DAB staining.

-
Immunohistochemical analysis of paraffin-embedded human rectal cancer tissues using SMARCA2 mouse mAb with DAB staining.

-
Immunohistochemical analysis of paraffin-embedded human ovarian cancer tissues using SMARCA2 mouse mAb with DAB staining.

鄂公网安备42018502007531号
鄂公网安备42018502007531号

